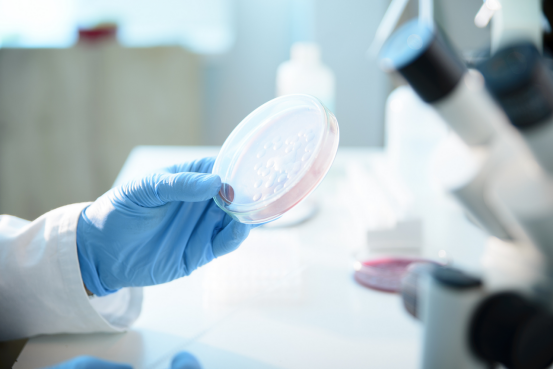
微生物实验室装修设计指南：博知行实验室带你解锁合规与实用双重标准

百科
专业的实验室、洁净室、动物房等专业场所的系统工程解决方案提供商
在实验室设计、实验室建设与实验室装修的全流程中,实验室试验台作为核心硬件设施,直接影响科研操作的便利性、安全性与效率。一款优质的实验室试验台,既能适配多样的实验需求,又能与实验室整体环境协调统一。博知行实验室深耕实验室建设领域,在实验室试验台研发、定制与安装方面积累了丰富经验,本文将拆解优质实验室试验台的核心选购要点,助力科研机构打造实用与安全兼具的实验空间。
研发实验室作为企业创新的核心引擎,其建设质量直接影响科研效率与成果转化。博知行实验室深耕实验室设计、实验室建设、实验室装修领域多年,积累了丰富的研发实验室打造经验。本文将从多个关键维度,详解研发实验室建设的核心要求,为企业打造功能完善、安全高效的科研空间提供参考。
在生物科研、医药研发、疾控检测等领域,微生物实验室的设计建设直接关系到实验数据的准确性、操作人员的安全性以及环境的合规性。一个科学规范的微生物实验室,不仅要满足国家相关标准,更要适配实际实验需求,实现 “安全、洁净、高效” 的核心目标。博知行实验室深耕实验室设计领域多年,结合丰富的项目经验与行业规范要求,总结出微生物实验室装修设计的核心要点,从平面布局到细节配置,全方位为你打造合规实用的实验空间。
人员净化用室应根据产品生产工艺和空气洁净等级要求设置,不同空气洁净等级的医药洁净室(区)的人员净化用室宜分别设置,空气洁净等级相同的无菌洁净室(区)和非无菌洁净室(区),其人员净化用室应分别设置。
在科技创新日新月异的今天,理化实验大楼早已不是简单的 “实验空间”,而是支撑科研突破、培育专业人才、保障检测精准的核心载体。一座功能完善、安全环保、智能高效的理化实验大楼,能为科研与教学注入强劲动力,成为推动行业进步的隐形引擎。
从饮用水里的安全密码,到餐桌上的健康守护,从纳米材料的神奇特性到太阳能电池的效率突破,这些看似遥远的科技进步,都离不开理化实验室的默默耕耘。这个集物理与化学智慧于一体的 “科学殿堂”,不仅是探索物质本质的圣地,更是连接理论与现实的桥梁,用一次次精准实验,为生活注入科技温度。
化学分析实验室是各类药品检验时的样品处理、试剂配制、滴定分析等的综合工作之地,是主要的分析检测场所,占地面积相对较大。为了方便操作,应与干燥室、天平室、仪器室等邻近。
因制药企业的规模、仪器装备的水平、检测的方法等,以及企业管理制度、操作习惯的不同,每个企业的质量控制区的建筑布局也会不同,而且随着法规的发展,药品的质量检测也在不断引进新方法、新技术以及先进的仪器设备,对质量控制区的布局的要求也在不断的发展。
技术要求检验、留样观察以及其他各类实验室应与药品生产区分开设置。 阳性对照、无菌检查、微生物限度检查和抗生素微生物检定等实验室,以及放射性同位 素检定室等应分开设置。 无菌检查室、微生物限度检查实验室应为无菌洁净室,其空气洁净度等级不应低于 B 级,并应设置响应的人员净化和物料净化设施
洁净工作台是一种设置在洁净室内或一般房间内,在操作台上保持高洁净度的局部净化设备,主要由预过滤器、高效过滤器、风机机组、静压箱、外壳、台面和配套的电器元器件组成,应根据产品生产要求或其他用途的要求进行选型。